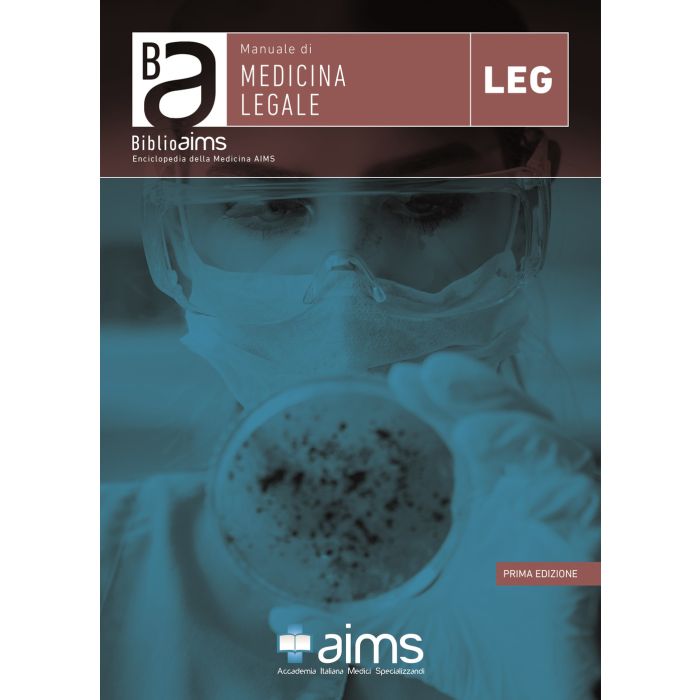

Manuale di medicina legale
calcActive())">
- ISBN/EAN
- 9788833410357
- Editore
- Accademia It. Medici Spec.
- Collana
- BiblioAIMS. Enciclopedia della Medicina AIMS
- Formato
- Libro rilegato
- Anno
- 2019
- Pagine
- 47
Non Disponibile
35,00 €
39,00 €
Il "Manuale di Medicina Legale" fa parte della collana enciclopedica BiblioAIMS - Enciclopedia della Medicina AIMS e tratta gli argomenti in modo schematico, sintetico e aggiornato in base alle più recenti linee guida, consentendo uno studio rapido della disciplina. L'intera Opera Enciclopedica è corredata da una grande varietà di immagini e schemi, pensati per facilitare la comprensione e la memorizzazione degli argomenti trattati.
Maggiori Informazioni
| Autore | Ciavarella Mauro;Trecca Eleonora Maria Consiglia |
|---|---|
| Editore | Accademia It. Medici Spec. |
| Anno | 2019 |
| Tipologia | Libro |
| Collana | BiblioAIMS. Enciclopedia della Medicina AIMS |
| Lingua | Italiano |
| Stato editoriale | Fuori catalogo |
Questo libro è anche in:
